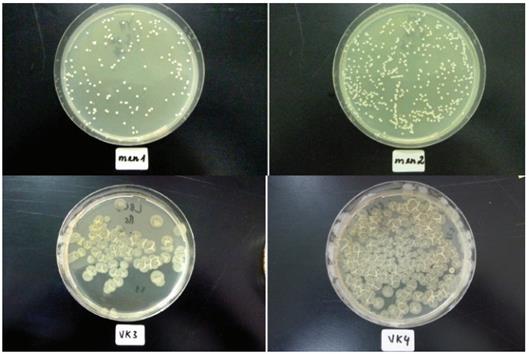

Chia sẻ nội dung:
- Việt Nam là một trong những quốc gia NTTS lớn trên thế giới; trong vòng 10 năm trở lại đây, sản lượng tôm sú, cá tra đã tăng lên nhanh chóng.

Do nuôi thâm canh với mật độ cao nên nước và bùn đáy các hồ ao bị ô nhiễm. Hiện nay, để xử lý sự ô nhiễm, các chế phẩm sinh học trên thị trường đã mang lại những kết quả đáng khích lệ; tuy nhiên thành phần trong môi trường nuôi các vi sinh vật hữu ích luôn cần pepton và thường phải nhập khẩu, nên giá thành tốn kém. Trong khi đó, Việt Nam đã có cơ sở nuôi trồng, sản xuất tảo xoắn (Spirulina); bột tảo xoắn (Spirulina powder) giàu protein, có giá trị cao trong dinh dưỡng. Một số môi trường nuôi vi sinh vật qua khảo sát cho thấy, có thể sử dụng bột tảo xoắn thay thế pepton mang lại kết quả tốt.
1. Đặt vấn đề
Những năm gần đây tảo xoắn (Spirulina platensis Geitl.) lôi cuốn sự chú ý của nhiều nước trên thế giới. Sự chú ý đó có cơ sở bởi, tảo xoắn giàu protein và chứa các thành phần dinh dưỡng khác có giá trị rất cao [1, 3, 6] đã được ứng dụng trong nhiều lĩnh vực của đời sống và sản xuất, xử lý môi trường [2,5,8]. Pepton là nguyên liệu được chuyển hóa bằng men pepsin hoặc bằng axit từ các loại protein động vật hoặc thực vật [4]. Peptone có khối lượng phân tử thấp, nên ngăn cản chúng khỏi bị kết tủa bởi muối hoặc kết tụ lại, điều đó cần cho việc tạo ra một môi trường đồng thể để nuôi cấy vi sinh vật. Kết quả, chúng hòa tan và nhờ thế được sử dụng rộng rãi trong các môi trường nuôi cấy [4,7]. Tuy nhiên, hiện nay pepton được sử dụng nhiều nhưng vẫn là thứ hàng hóa phải nhập nội.
Để đáp ứng được nhu cầu trong sản xuất nguồn giồng vi sinh vật phục vụ cho xử lý nước thải NTTS chúng tôi đã sử dụng bột sinh khối tảo Spirulina để thay thế pepton. Bởi lẽ như trên đã đề cập, tảo Spirulina có hàm lượng protein thuộc vào loại cao nhất trong thực phẩm hiện nay, 55 - 70%, cao hơn 3 lần thịt bò, hơn 2 lần trong đậu tương. Spirulina được sử dụng như một thực phẩm bổ sung hoặc toàn bộ thức ăn. Sinh khối tảo và bột tảo được sử dụng làm thức ăn bổ sung trong ngành NTTS và gia cầm [3, 7]… Dạng bột tảo (Spirulina powder) có nhiều chất dinh dưỡng cần thiết, đặc biệt là protein, Vitamin B1 (thiamin), B2 (riboflavin), Cyanocobalamin (B12) các khoáng chất, chẳng hạn như sắt, mangan.. [5, 6]
Với thành phần hóa học như đã nêu, việc sử dụng Spirulina thay pepton là khả dĩ, rất cần thiết cho môi trường nuôi cấy; trong khi, pepton phải nhập nội mà nguồn bột tảo xoắn của nước ta phong phú có chất lượng cao thì sự thay thế pepton bằng bột tảo để nuôi vi sinh vật ở nước ta trong điều kiện kinh tế hiện nay là cần thiết và có ý nghĩa.
2. Phương pháp nghiên cứu

2.1. Pha chế các môi trường thường dùng trong nuôi cấy (media culture) VSV
2.2. Các chủng vi sinh vật sử dụng trong nghiên cứu: Saccharomyces cerevisiae, Bacillus subtilis, Lactobacillus licheniformis thuộc tập đoàn giống của Trung tâm BIOLAP.
2.3. Pha chế các môi trường “mới” (MT*) có bột sinh khối Spirulina thay cho pepton có cùng khối lượng
- Môi trường YM* để nuôi cấy Saccharomyces cerevisiae
- Môi trường LB* để nuôi Bacillus subtilis
- Môi trường MRS* để nuôi Lactobacillus licheniformis
Các môi trường đều được thanh trùng ở 1210C trong 20 phút.
2.4. Cấy các chủng vi sinh vật (VSV) có cùng mật độ như nhau vào các môi trường “mới” tương ứng và được thực hiện trong phòng cấy, thanh trùng bằng đèn tử ngoại (UV lamp).
2.5. Nuôi các chủng VSV trên trong cùng một điều kiện của phòng thí nghiệm. Các nhóm VSV khi mọc trên môi trường thạch (MT và MT*) và hình thành các khuẩn lạc và được xác định số lượng theo phương pháp CFU (colony-forming unit). Các tiêu bản được ghi lại trên kính hiển vi điện tử.
3. Kết quả nghiên cứu

Từ kết quả ở bảng cho thấy:
a, Sử dụng môi trường YM làm môi trường nuôi Saccharomyces cerevisiae cho thấy: Trên môi trường YM có kết quả là: 2,8 x 109 CFU/ml, còn trên môi trường YM* (số 2) thay thế pepton bằng bột Spirulina: có 0,428 x 109 CFU/ml. Số CFU ở đây thấp hơn môi trường YM. Trên môi trường YM* (số 3) thay thế pepton bằng bột Spirulina x1,5 có số khuẩn lạc là 3,1 x 109 tương đương với môi trường YM.
b. Nuôi Bacillus subtilis trong môi trường LB cho số khuẩn lạc là: 7,5 x 109 CFU/ml. Trên môi trường LB* thay thế pepton bằng bột Spirulina cho số khuẩn lạc gần giống như môi trường LB 2,3 x 1010CFU/ml.
c. Nuôi Lactobacillus trong môi trường MRS cho số khuẩn lạc là: 3,8 x 107 CFU/ml. Trên môi trường MRS* chuẩn thay thế pepton bằng bột Spirulina cho số khuẩn lạc : 3,6 x 107 CFU/ml.
d. Ảnh chụp dưới kính hiển vi không thấy có sự sai khác về hình ảnh các chủng VSV. Saccharomyces trên môi trường YM (men1) và môi trường YM* (men2) sau 48 giờ. Bacillus subtilis trên môi trường LB (vk 3) và môi trường LB* (vk 4) sau 24 giờ.
4. Kết luận
Khi thay pepton bằng bột tảo Spirulina vào các môi trường LB, MRS với khối lượng tương đương để nuôi cấy các chủng vi sinh vật Bacillus subtilis, Lactobacillus licheniformis ở điều kiện như nhau, kết quả cho thấy không có sự sai khác về sự phát triển và hình thái khuẩn lạc. Với chủng Saccharomyces cerevisiae cần tăng thêm khối lượng bột tảo. Như vậy việc thay pepton bằng bột sinh khối Spirulina có kết quả trong một số môi trường phát triển nuôi VSV hữu ích mang lại lợi ích cho người sản xuất.
Tài liệu tham khảo
1. Dương Đức Tiến, 2009. Sản xuất thực phẩm sạch giàu dinh dưỡng từ tảo Spirulina tại Hà Nội, Báo cáo tổng kết Dự án P-2007-01
2. Lâm Minh Triết, 1990. Xử lý nước thải hồ sinh vật với sự tham gia của tảo và bèo lục bình ở Việt Nam. Tuyển tập báo cáo khoa học của Trung tâm Nước và Môi trường, ĐHBK TP Hồ Chí Minh, trang 160-1.
3. Nguyễn Hữu Thước, 1988. Tảo Spirulina-nguồn dinh dưỡng và dược liệu quý. NXBKHKT, Hà Nội.111 tr.
4. Peptone. Bibliographisches Institut & F. A. Brockhaus AG, 2008, archiviert vom Original am 5. Dezember 2008; abgerufen am 4. November 2014.
5. Rezaei H., 2013. Biosorption of chromium by using Spirulina sp., Arabian Journal of Chemistry 9(6):846-853.
6. Richmond A., Hu Q., 2013. Handbook of microalgal culture: applied phycology and biotechnology. Second edition. Blackwell Publishing Ltd:719.
7. Tokusoglu, O.; Unal, M.K. (2003). "Biomass Nutrient Profiles of Three Microalgal: Spirulina platensis, Chlorella vulgaris, and Isochrisis galbana". Journal of Food Science. 68 (4): 2003. doi:10.1111/j.1365-2621.2003.tb09615.x.
8. Worku A., Sahu O.,2014.Reduction of Heavy Metal and Hardness from Ground water by Algae.Journal of Applied &Environmental Microbiology.2(3):86-89.